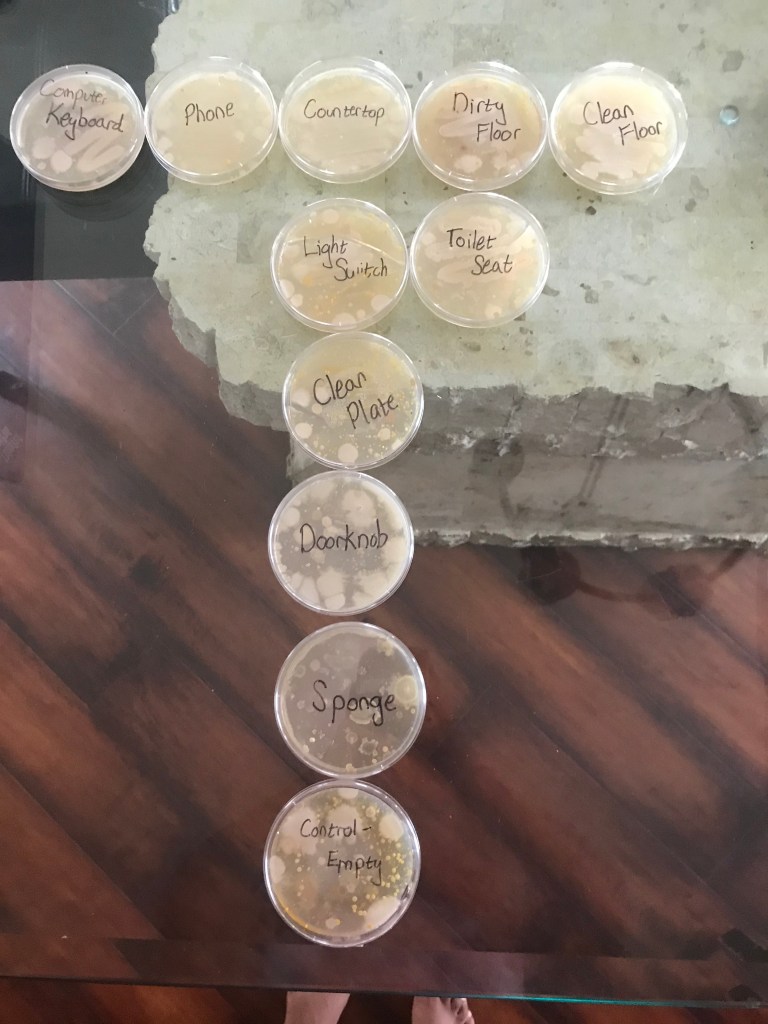

Can people match parents to their respective children?
Experiment:
When my parents meet relatives that have recently had children, they often make the same kind-spirited remark: “Oh, you look just like them!” To me, babies look nothing like their parents, until they grow older and grow more defined facial features. My hypothesis is that people can not assign parents to their children based on facial features alone. To test this over the course of the month, both in school, and at home, I created a google form that asked respondents to match a picture of parents to a group of 5 babies, with only one being the couple’s child. Then I would have respondents pick, out of that pool of babies, which baby belonged those specific parents. The strategy I used was finding young pictures of celebrities, then finding that celebrity’s parents. This would make the pictures easier to find, while making sure no one would recognize any of the faces. 
Challenges & Rewards:
Of course, I wanted a significant number of questions to have a large sample size. I decided on 20 questions, with five options for each question. However, this meant that I would have to find over 100 pictures of babies and their parents. Each question had to have babies that could believably be related to the parents. This search resulted in weeks of finding, deleting, and putting together pictures, at school to put on the quiz. I scoured the internet for pictures, cross referencing and making sure I had no repeats I had to make sure the pictures I had were accurate, while also making sure there were no obvious answers. This extreme lapse in productivity soon paid off, because, once I distributed the quiz to my friends and fellow students, I received over 90 responses. This means that overall, that with 20 questions each, I had collected over 1800 data points. A link to the final product is below

Link to the quiz: https://forms.gle/gzTQg7EA76fPRwWy5
Results:
The quiz ended up being spread to all corners of the U.S, from Seattle to New York. It even reached 4 continents, traveling to London, Sri Lanka, and Australia. By the end, I had 91 respondents total. For the hypothesis proposed by my parents to be correct, people should get more questions right than wrong. Therefore, if the average respondent gets more than 50%, or more than 10 questions correct out of 20, my parents will be correct according to this experiment. Out of the 91 respondents, the average number of questions people got correct was 5.52. By the laws of probability, if you were to simply guess each answer randomly, you would get a score of 4/20, or 20%. Therefore, it is clear that the respondents barely completed the test better than if they were to pick answers at random. In fact, over 25% of the participants received a score lower than if they were to pick at random. The respondents did far worse than the over 10 question benchmark, making my hypothesis, in this case, true. Below one can see the data, in bar graph and box and whisker plot form, as well as other data points.


Conclusion:
So why do we see the similarities in parents and their children when we clearly can’t identify them? The reason traces back to our ancient ancestors. Back then, recognizing patterns in others faces to see if they posed a threat or were likely to cooperate meant life or death. Therefore, we humans got exceptionally good in recognizing patterns in others faces. Being able to recognize and empathize with others helped us build the long lasting civilizations and communities that define modern life. So next time you see your baby cousin, know that you probably can’t tell that she, “..looks just like you!”, but the fact that you can identify and recognize these faces at all is a testament to the incredible power of the human brain.